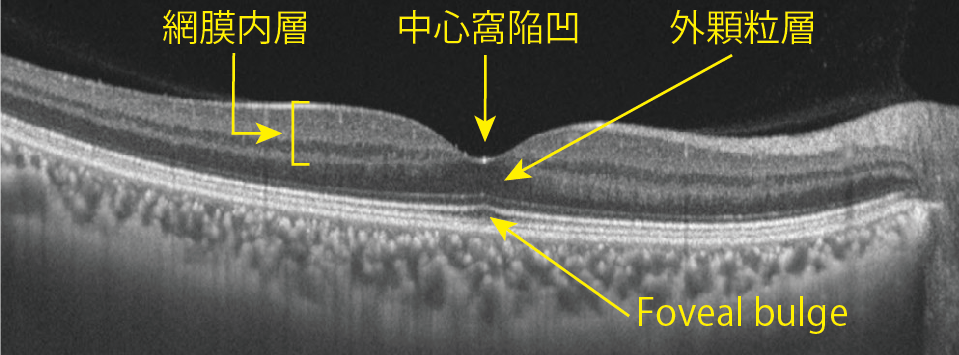

oculocutaneous albinism 眼皮膚白皮症https://meisha.info/archives/2772やocular albinism 眼白皮症(眼白子症)https://meisha.info/archives/2783における視力不良や眼振は、正常な中心窩が形成されない黄斑低形成 foveal hypoplasiaが原因です。
近藤寛之: 黄斑低形成. 日本眼科学会雑誌 125:695-708.2021
黄斑の中央、直径1.5 mmの陥凹である中心窩https://meisha.info/archives/4066には以下の特徴があることの理解が重要です。
陥凹が始まる屈曲部のエッジが若年者の眼底ではリング状の反射として観察されます。

OCT画像では下記①から④の所見(図)が、中心窩においてみられます。
① 網膜内層の欠如
発生過程で、網膜内層の神経細胞が中心窩から遠心性に周辺に移動するためで、その結果として
② 中心窩陥凹
を生じています。
③ 外顆粒層の肥厚
網膜内層とは逆に錐体細胞が中心窩に向けて求心性に移動し密集した結果です。
④ foveal bulge
錐体細胞の内節と外節が、中心窩では伸長するためEZとELMがテント状に隆起する所見です。
短波長光の自発蛍光(FAF)像(図左)では中心窩は周囲よりも低蛍光になります。
これは中心窩視細胞から周辺に移動した双極細胞へ、放射状に向かう軸索で形成される外網状層(ヘンレ線維層)に黄斑色素が多く含まれていて、これが網膜色素上皮からの波長の短い自発蛍光を通しにくいためです。

血管形成を促進するアストロサイトの中心窩への移動を、中心窩のミュラー細胞の塊(Muller cell cone)が阻止するため、中心窩には網膜内層を栄養する網膜血管(網膜中心動脈の枝)が分布しません。
そのため網膜内層のOCTAやフルオレセイン蛍光造影写真では毛細血管網が欠如するfoveal avascular zone: FAZ(上図右)が種々のサイズで観察されます。